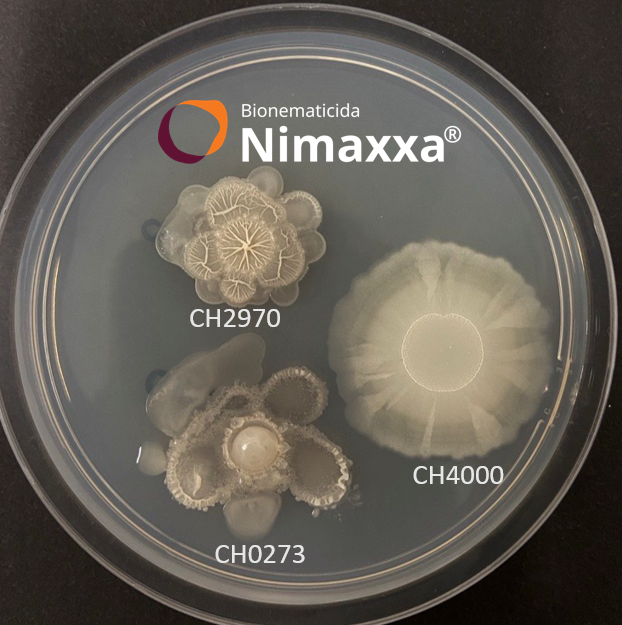
upl-bionematicida-bioestimulante-nimaxxa

Publicado em: 01/08/2024 às 07:00hs
A UPL Ltd. (NSE: UPL, BSE: 512070, LSE: UPLL), uma fornecedora global de soluções agrícolas sustentáveis, alcançou um marco significativo ao obter o registro do primeiro bionematicida bioestimulante agrícola no Brasil. O produto, chamado Nimaxxa, que já era conhecido como um nematicida biológico, agora também é reconhecido como bioestimulante, após testes e validações que comprovaram sua eficácia na estimulação do crescimento das plantas e aumento da produtividade dos cultivos. O novo registro foi oficializado pelo Ministério da Agricultura e Pecuária (Mapa).
O Nimaxxa faz parte do portfólio da Natural Plant Protection (NPP), a unidade de negócios da UPL especializada em biossoluções. O produto é composto por três cepas de bactérias do gênero Bacillus: B. paralicheniformis, B. paralicheniformis e B. subtilis. Essas cepas, exclusivas da UPL, atuam de maneira complementar para oferecer tanto proteção quanto estimulação ao crescimento das plantas.
Rogério Castro, CEO da UPL Brasil, destaca: "Esta conquista é um reflexo de nossa estratégia contínua em desenvolver soluções focadas no agricultor, cuja missão é produzir para alimentar o planeta. Este marco não só evidencia o potencial e a robustez de Nimaxxa, como também reforça a meta global da UPL de ser líder em sustentabilidade, tecnologia e inovação."
Bruno Carloto, gerente de tratamento de sementes e saúde do solo da UPL Brasil, complementa: "Nimaxxa é uma demonstração concreta do conceito exclusivo da UPL, o OpenAg, que nos transforma em uma rede colaborativa e aberta de inovação agrícola. Esta biossolução representa um avanço tecnológico significativo, proporcionando estimulação que realmente resulta em maior produtividade de forma sustentável. O novo registro é um reflexo de nosso consistente investimento e pioneirismo no setor."
Carloto explica que as três cepas biológicas no Nimaxxa colonizam rapidamente as raízes das plantas, formando um biofilme que persiste durante todo o ciclo da cultura. Esse biofilme protege as plantas contra principais nematoides, como o nematoide do cisto, das galhas e das lesões, além de oferecer um efeito bioestimulante, conforme comprovado pelo registro obtido junto ao Mapa após o rigoroso processo regulatório.
Uma vantagem adicional do Nimaxxa é sua validade de 2 anos sem necessidade de refrigeração, um avanço tecnológico notável para produtos biológicos. Além disso, possui alta compatibilidade com insumos químicos, podendo ser misturado com todos os tratamentos de sementes disponíveis no mercado. Sementes tratadas com Nimaxxa, resultado de uma colaboração entre UPL e Novonesis, uma empresa global especializada em biossoluções, podem ser armazenadas por até 6 meses sem perda de viabilidade.
Fonte: Portal do Agronegócio
◄ Leia outras notícias